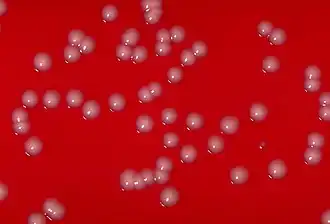
Description de cette image, également commentée ci-après

Mycobacteriales
| Domaine | Bacteria |
|---|---|
| Règne | Bacillati |
| Phylum | Actinomycetota |
| Classe | Actinomycetes |
- Corynebacteriales Goodfellow & Jones 2015 (nom. illeg.)
- Mycobacteriales Cavalier-Smith 2002 (nom. illeg.)
Les Mycobacteriales sont un ordre de bactéries à Gram positif de la classe des Actinomycetes. Il comprend plusieurs genres dont certaines espèces sont des pathogènes humains tels que Corynebacterium, Mycobacterium ou encore Nocardia.
Taxonomie
L'ordre des Mycobactériales a été décrit en 1924 par Janke[1] et amendé par Gupta et al. en 2019[2]. Les familles membres de cet ordre forment un clade monophylétique dans les arbres phylogénétiques basés sur l'analyse du gène de l'ARNr 16S et sur de grands sets de données de séquences protéiques[2].
Le genre type de cet ordre est le genre Mycobacterium (Lehmann and Neumann, 1896) (Approved Lists 1980) amendé par Gupta et al. en 2018[2].
Phylogénie
La taxonomie actuellement[Quand ?] acceptée est basée sur la LPSN[3],[4]. La phylogénie est basée sur l'analyse du génome entier des bactéries appartenant aux familles comprises dans cet ordre[5].
Liste de familles
- Corynebacteriaceae Lehmann & Neumann 1907
- Dietziaceae Rainey et al. 1997
- Gordoniaceae Rainey et al. 1997
- Lawsonellaceae Nouioui et al. 2018
- Mycobacteriaceae Chester 1897
- Nocardiaceae Castellani & Chalmers 1919
- Segniliparaceae Butler et al. 2005
- Speluncibacteraceae Lee et al. 2024
- Tsukamurellaceae Rainey et al. 1997
Références
- (en) Cet article est partiellement ou en totalité issu de l’article de Wikipédia en anglais intitulé « Mycobacteriales » (voir la liste des auteurs).
- 1 2 Janke A. (1924). Allgemeine technische Mikrobiologie. I. Teil. Die Mikroorganismen [General Technical Microbiology. Part I. The Microorganisms.] (1st ed.). Dresden and Leipzig: T. Steinkopf.
- 1 2 3 (en) RS Gupta, « Commentary: Genome-Based Taxonomic Classification of the Phylum Actinobacteria », Frontiers in Microbiology, vol. 10, , p. 206 (DOI 10.3389/fmicb.2019.00206, lire en ligne)
- ↑ (en) « Order: Mycobacteriales », sur List of Prokaryotic names with Standing in Nomenclature (consulté le )
- ↑ Euzéby JP, Parte AC.
- ↑ (en) Nouioui I, Carro L, García-López M, Meier-Kolthoff JP, Woyke T, Kyrpides NC, Pukall R, Klenk H-P, Goodfellow M, Markus Göker M., « Genome-Based Taxonomic Classification of the Phylum Actinobacteria », Front. Microbiol., vol. 9, , p. 2007 (PMID 30186281, PMCID 6113628, DOI 10.3389/fmicb.2018.02007)
- ↑ List of Prokaryotic names with Standing in Nomenclature (LPSN), consulté le 14 mai 2025.
Liens externes
- (en) AlgaeBase : ordre Mycobacteriales Janke (+classification) (consulté le )
- (en) Catalogue of Life : Mycobacteriales Janke, 1924 (Approved Lists 1980) (consulté le )
- (fr + en) EOL : Mycobacteriales (consulté le )
- (fr + en) GBIF : Mycobacteriales (consulté le )
- (fr) INPN : Mycobacteriales Janke, 1924 (TAXREF) (consulté le )
- (en) LPSN : Mycobacteriales Janke 1924 (consulté le )
- (en) NCBI : Mycobacteriales (taxons inclus) (consulté le )
- Portail de la microbiologie
- Portail de la médecine